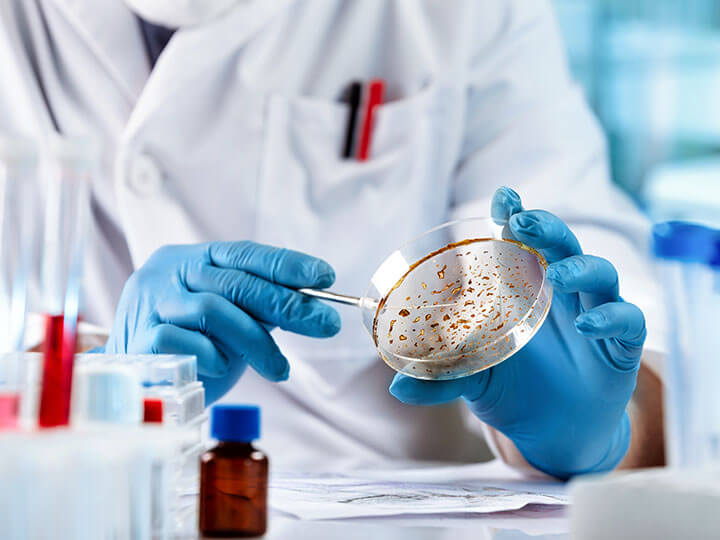
Microbiologist wearing protective blue gloves examining mold in petri dish in a laboratory

The Hidden Dangers of Mold and How it Impacts Commercial Buildings

18 Mar 2025
Effective Strategies for Prevention, Remediation, and Long-Term Protection
Mold growth in commercial buildings compromises both health and structural integrity, making it a critical concern for property owners, occupants, and visitors alike. Mold infestation can escalate quickly if not addressed, leading to respiratory issues, allergic reactions, and other health complications. Additionally, prolonged mold exposure can weaken building materials, resulting in costly repairs and potential legal liabilities. Understanding the dangers of mold and how to prevent it in commercial spaces is crucial for ensuring a safe and healthy work environment.
How Mold Grows and Spreads
For mold to thrive, three key factors must be present: heat, food, and moisture. Since most commercial buildings maintain temperatures comfortable for humans, they inadvertently create an ideal environment for mold. Organic materials such as drywall, wood, carpeting, insulation, and even dust and food particles serve as food sources for mold, allowing it to spread quickly.
However, moisture is the most significant and controllable factor in mold prevention. Common sources of excess moisture include plumbing and roof leaks, HVAC malfunctions, flooding, poor drainage, and inadequate ventilation. If moisture issues are not addressed within 48 to 72 hours, mold can rapidly spread, affecting air quality, occupant health, and building materials, leading to costly remediation.
Health Risks of Mold Exposure
Mold exposure affects individuals differently. While some may experience mild symptoms such as sneezing, itchy eyes, and respiratory irritation, others especially those with allergies, asthma, or weakened immune systems, can suffer from more severe health effects.
Certain molds, including Stachybotrys (black mold), Penicillium, and Aspergillus, produce mycotoxins that can worsen respiratory conditions. Aspergillus, in particular, can cause aspergillosis, a serious lung infection in immunocompromised individuals. Long-term mold exposure can contribute to chronic respiratory issues, skin irritation, and cognitive effects in extreme cases.
In commercial settings, prolonged mold exposure can lead to employee absenteeism, tenant complaints, and potential liability concerns, making proactive mold management critical.
Detecting Mold in Commercial Buildings
Early detection helps prevent significant damage and costly remediation. Some of the most common signs of mold include visible growth on walls, ceilings, carpeting, or furniture, as well as musty or damp odors near HVAC systems, basements, or plumbing fixtures. Water stains or discoloration on ceilings and walls often indicate past or ongoing moisture issues, while increased humidity levels suggest HVAC systems may not be properly dehumidifying the space.
Since mold can also grow in hidden areas inside walls, beneath flooring, and in air ducts, regular inspections by property managers or environmental professionals are essential for early intervention.
Steps for Mold Remediation
If mold contamination is found, eliminating the source of moisture is the first and most crucial step. Without addressing underlying leaks or humidity issues, mold is likely to return.
For small mold-affected areas (less than 10 square feet), cleaning with EPA-approved mold removal solutions is often effective. However, larger infestations typically require professional remediation. This may include containing the affected area, using negative air pressure systems to prevent mold spores from spreading, and removing or replacing contaminated materials such as drywall, carpeting, and insulation. Non-porous surfaces can usually be cleaned and treated with antimicrobial solutions.
While some remediation efforts involve applying antimicrobial coatings, the most effective long-term solution is eliminating moisture sources, improving ventilation, and implementing routine maintenance protocols.
Preventing Mold in Commercial Spaces
Proactive mold prevention is essential to maintaining a safe and healthy indoor environment. Commercial building owners and facility managers should implement routine maintenance strategies to minimize the risk of mold growth. Regular HVAC maintenance, including cleaning air ducts, filters, and dehumidifiers, helps prevent excess humidity buildup. Frequent plumbing inspections allow for early leak detection and repair before they lead to water damage. Properly sealing windows, doors, roofing, and foundations reduces the risk of water intrusion, while keeping gutters and downspouts clear helps with drainage and prevents water pooling around the building. Maintaining indoor humidity levels between 30% and 50% further discourages mold development and supports overall air quality.
Beyond maintenance, educating employees and building occupants on the early signs of mold and moisture issues encourages timely reporting and intervention.
Intertek partners with clients to protect buildings and their occupants from moisture-related issues and microbial growth. Our team provides comprehensive assessments, remediation oversight, and proactive prevention strategies. Learn more about how Intertek helps mitigate mold-related risks.